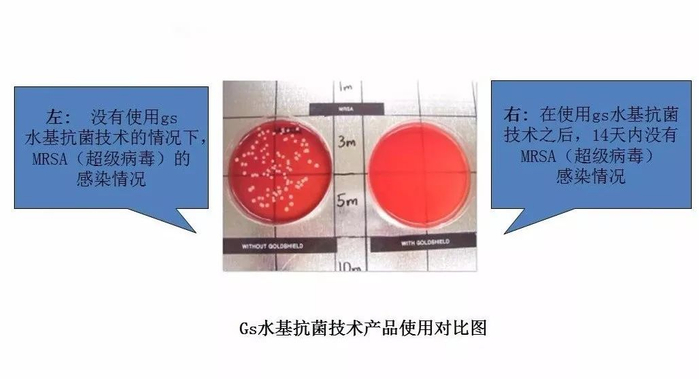

又是一年要过去了,抢车票、买年货...回家的脚步越来越近。
话说,2020年是开启20年代的第一年,也是12生肖又轮回的第一年,势必红红火火,恍恍惚惚啊~

新年新气象,为了给自己讨个好彩头,身边的伙伴们纷纷把红球鞋、红手绳、红袜子、红内裤...安排上了。
Christian Dior 先生说:“热爱红色,因为红色是生命的颜色。”
新年来点“红”运,不只是约定俗成,也是一种新年伊始的仪式感。
所以,一条能召唤好运、驱邪添福的红内裤也是必不可少的!

这款能为好运加持的男士招财猫大红内裤就不一样了。
新年鸿运招财设计,原创小招财猫图案,寓意来年财源滚滚。

面料采用美国FDA认证的抗菌技术,内裆抗菌率在99%以上。
整体一片式的设计,无缝裁剪贴合,裸感穿着,舒适透气。

选择这款健康、幸运的内裤,自穿,送人都很合适,红红火火过大年。
△点击上方图片即可购买△
89元/2条 起
内裤一直以来的样子,都不太出格。
毕竟,日常穿就图个舒服,别人也看不到,自然也没必要讲究款式。
但时代变了,基本需求满足以后,自然就要追求更高的享受。

尤其是本命年的红内裤,必须得讲究!

大红的底色,点缀上招财猫、祥云和中国结的样式,沉稳又不失大气。
新年鸿运招财设计,原创小招财猫图案,寓意来年财源滚滚。

绅士,是一种由内而外的修养。
这样一条好看的大红内裤,自穿送人,都很合适。

△点击上方图片即可购买△
89元/2条 起

能保持卫生的内裤,才是好内裤呀!

面料不起球不刺痒,50支的面料,90%粘胶,滑到皮肤都挂不住。
试穿了之后,发现这种面料更柔软,更轻薄,而且非常透气,简直像是会呼吸!

把内裤罩在加湿器上,气雾能顺利无阻地通过裤身。
黏腻、异味统统都不存在!
要滑嫩柔软,也要弹性十足。

腰部采用无痕熔压腰带,无感贴合,高弹舒适,回弹性好,大力拉扯都不会变形。
腰身比较发福的人穿着也不会有紧绷的感觉。

裆部采用3D剪裁,立体式囊袋,舒适不紧勒。
关键部位被稳稳护住,又有足够的自由。

一片式的设计,整体采用无缝裁剪贴合,浑然一体。
更加贴合人体曲线,带来近乎裸感的穿着。

防夹臀设计,坐久了内裤也不会卡到缝里,可以说相当贴心了~
舒适感强,不憋闷。

健康着色,环保且对身体无害。
用开水洗它,搅拌,也没脱色。

精美的礼盒包装,吉祥如意,平安祈福。
过年回家,送给本命年的亲朋好友,传递好运,也很合适。
性价比方面也很高,有两种组合方式可以选择。

内裤的尺码方面可以参照尺码表。
新的一年来临,这款能带来好运的高品质招财猫内裤可以安排一下。


